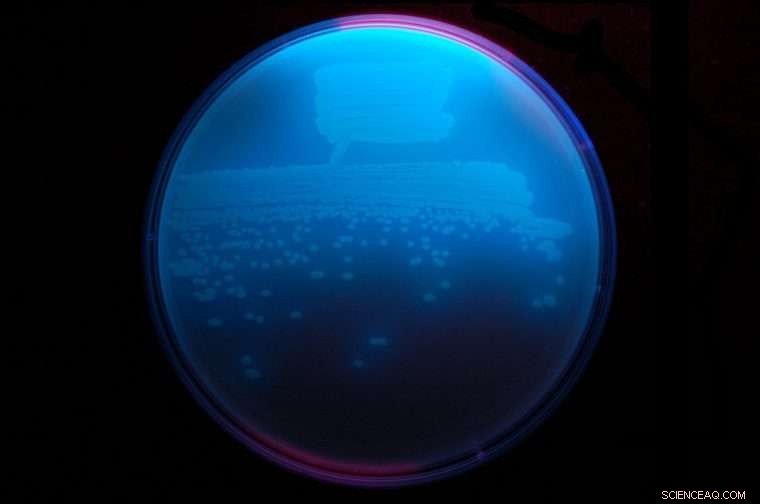
Rapid Antibiotic Synthesis: Lab Mimics Bacterial Enzymes to Create a New Clean, Efficient Drug Class

The soil bacterium Pseudomonas fluorescens, here glowing brightly under ultraviolet light, exudes an antibiotic called obafluorin that has a novel ß-lactone structure. Credit: Washington University in St. Louis
The active component of the wonder drug penicillin and related antibiotics such as the cephalosporins is an "enchanted ring," called the β-lactam ring. Antibiotics that include these rings are arguably the most important drugs in human history, having singlehandedly increased global life expectancy by an estimated five years.
"People often say we're running out of antibiotics, but there are more than 20,000 molecules with antibiotic activity in the Handbook of Antibiotics," said Timothy Wencewicz, a chemist at Washington University in St. Louis who specializes in antibiotic design.
"Fewer than 1 percent of those has ever been considered as a potential clinical candidate. They languish because it takes so much time and care to prepare a molecule for use as a pharmaceutical.
Wencewicz carefully chose one of these molecules, obafluorin, for further study. Oblafluorin, discovered in 1984 by the Squibb Institute, is made by a fluorescent strain of soil bacteria that forms biofilms on plant roots.
Like penicillin, obafluorin has a four-membered ring. A four-membered ring puts strain on the bond angles that carbon prefers to adopt, explains Wencewicz. "The strain turns these rings into molecular bombs that go off when they are put in the right place at the right time, which is useful for killing microbes," he said.
But because a four-member ring is unstable, these molecules are also short lived and hard to make. It took years for chemists to learn how to synthesize penicillin from chemicals and then to figure out how fungi make it. The antibiotic is still made by fermenting a penicillin-exuding strain of fungus in giant stainless steel vats.
The Wencewicz lab was able to leapfrog the whole process, using genetics to zero in on the biosynthetic machinery that bacteria use to make obafluorin and then to reconstruct that multi-step, enzyme-catalyzed process in the lab.

The beta-lactam ring couples three carbons and a nitrogen, whereas the beta-lactone ring consists of three carbons and an oxygen. "They're essentially iso-electron; they look and smell the same," Wencewicz said. "But oxygen is different from nitrogen, and so they have a different palette of bioactivities and inhibit a different set of target enzymes." Credit: Wencewicz
Wencewicz, graduate students Mars Reck and Jason Schaffer, and undergraduate Neha Prasad describe the complete biosynthetic machinery for the assembly of the ß-lactone obafluorin in the May 15 issue of Nature Chemical Biology.
The ß-lactones inhibit a large class of enzymes called the serine hydrolases. "There are hundreds of known serine hydrolases, and they are implicated in many human diseases," Wencewicz said. The ß-lactones may prove useful in the treatment of cancer and obesity, as well as infectious diseases.
A dark pathway brought to light
Obafluorin is a peptide, a short chain of linked amino acids. Most peptides are produced by a cellular machine called the ribosome, which makes a variety of peptides. Obafluorin, however, is assembled not by the ribosome but by non-ribosomal peptide synthetase (NRPS), a multi-part enzyme that synthesizes only one type of peptide.
The ribosomes make the long peptides called proteins that are crucial for life, Wencewicz said. Ribosomes have evolved over millions of years to be incredibly efficient and accurate, he added, but they use a limited set of amino-acid building blocks.
Antibiotics and other secondary metabolites that are useful but not essential for life are assembled more or less on demand by NRPS assembly lines. These NRPSs are able to link thousands of different amino acid building blocks to form structurally diverse small peptides with important biological activity.
NRPSs are essentially a series of enzymes strung together into one large protein with many domains, each of which carries out one step in peptide assembly. "They're rather like Henry Ford assembly lines," Wencewicz said.
The Wencewicz lab identified the gene cluster in Pseudomonas fluorescent that makes the NRPS and made the five enzymes the genes encoded.
The fifth enzyme turned out to be particularly interesting. It is an unusual thioesterase responsible for ß-lactone ring formation when the peptide is released from the NRPS. Unlike other thioesterase enzymes, the obafluorin thioesterase includes a rare catalytic amino acid that generates a reactive thioester intermediate. This unusual chemistry allows the NRPS to overcome the energy barrier that otherwise prevents the formation of a strained ring.
Many more rings to come
"We now have a complete enzymatic platform for making ß-lactone peptides from simple starting materials," Wencewicz said. "Since we know the gene sequences that code for this assembly line, we are using the power of modern genome sequencing to search for and make new ß-lactones made by other organisms."
Anyone familiar with the long and frustrating battle to produce enough penicillin to help wounded soldiers during World War II can only marvel at the breathtaking advances in genetics and chemistry that have allowed the Wencewicz lab to collapse the work of many decades into a few years.